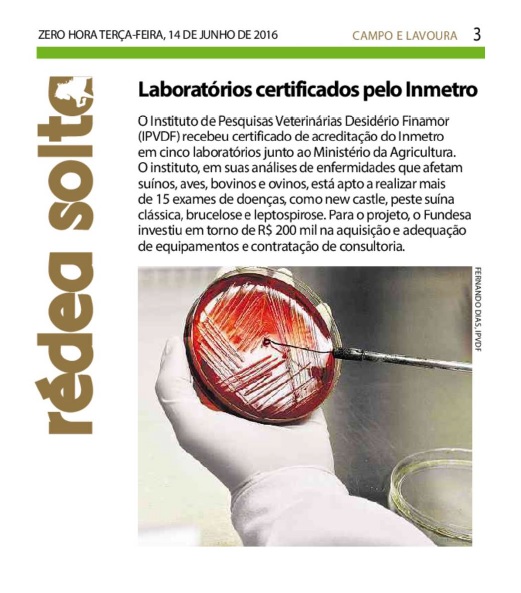

21/06/2016 – ZH: Setor lácteo brasileiro reúne-se hoje com o ministro da Agricultura

ZERO HORA | CAMPO ABERTO | PÁGINA 14 No radar – Setor lácteo brasileiro reúne-se hoje com o ministro da Agricultura, Blairo Maggi, em Brasília. Na pauta do encontro, políticas de apoio à exportação, publicação do novo registro de inspeção industrial e sanitária e aumento do número de fiscais agropecuários. Clique aqui e confira a […]
21/06/2016 – ZH: Sentindo a crise na carne

ZERO HORA | CAMPO E LAVOURA | PÁGINA 4, 5 E 6 Descompasso entre a alta dos insumos para ração de aves e suínos e dificuldade em repassar os aumentos resultam em perdas para os produtores A conta que não fecha entre a explosão dos custos de produção e a dificuldade para repassar preços diante […]
18/06/2016 – ZH: Especial – Quem são os donos de cães e gatos

ZERO HORA | ESPECIAL | SUA VIDA | PG 28 e 29 Pesquisa do IBOPE INTELIGÊNCIA traça perfil de quem escolhe ter um animal de estimação e como se comporta quando prefere gato ou cachorro Bolt não tinha nem dois meses quando tomou o primeiro voo. Em uma caixinha especial para o transporte de pets, o golden […]
17/06/2016 – ZH: Último dia para vacinar

ZERO HORA | CAMPO ABERTO | PÁGINA 26 Prorrogada por 17 dias, em razão do excesso de chuva, a campanha de vacinação contra a febre aftosa termina hoje no Rio Grande do Sul. Coordenadora do programa de combate à doença da Secretaria da Agricultura, Grazziane Rigon explica que além da imunização, outras ações são importantes […]
14/06/2016 – ZH: Último prazo para vacinação

ZERO HORA | CAMPO E LAVOURA | PÁGINA 7 Data para imunizar o rebanho bovino contra febre aftosa encerra na sexta. Estado já atingiu 92,3% dos cerca de 13,9 milhões de animais Os produtores têm até sexta-feira para vacinarem e comprovarem a vacinação do rebanho bovino e bubalino contra a febre aftosa no Estado. A […]
14/06/2016 – ZH: Laboratórios certificados pelo Inmetro
ZERO HORA | CAMPO E LAVOURA | PÁGINA 3 O Instituto de Pesquisas Veterinárias Desidério Finamor (IPVDF) recebeu certificado de acreditação do Inmetro em cinco laboratórios junto ao Ministério da Agricultura. O instituto, em suas análises de enfermidades que afetam suínos, aves, bovinos e ovinos, está apto a realizar mais de 15 exames de doenças, […]
09/06/2016 – ZH: Queijo mascarado

ZERO HORA | CAMPO ABERTO | PÁGINA 21 As primeiras análises das amostras coletadas na terceira fase da Operação Queijo Compen$ado, realizada há uma semana em sete cidades do Rio Grande do Sul, continham amido de milho e três bactérias diferentes. A adulteração do produto para mascarar uma quantidade menor de leite é confirmada pelo […]
07/06/2016 – ZH: Exame a cada seis meses

ZERO HORA | CAMPO ABERTO | PÁGINA 15 Os exames negativos de mormo passarão a ter validade de seis meses para a permissão de transporte e movimentação de cavalos no Rio Grande do Sul. A partir de uma análise de risco da incidência da doença, o governo do Estado decidiu alongar de 60 para 180 […]
03/06/2016 – ZH: Ação combate queijo adulterado

ZERO HORA | ECONOMIA | PÁGINA 14 Produto impróprio para consumo era revendido no Estado. Seis pessoas foram presas em operação em sete cidades Fabricantes e distribuidores de queijo foram alvos da terceira fase da Operação Queijo Compen$ado, deflagrada pelo Ministério Público Estadual (MP) ontem em Porto Alegre e outras seis cidades de norte, noroeste, […]
03/06/2016 – ZH: Disfarce no queijo

ZERO HORA | CAMPO ABERTO | PÁGINA 22 Com mais de cem marcas de produtos lácteos no mercado gaúcho, o consumidor deverá ficar ainda mais criterioso na hora de escolher seu queijo. Na terceira fase da Operação Queijo Compen$ado, deflagrada ontem pelo Ministério Público em sete cidades do Rio Grande do Sul (Leia mais na […]